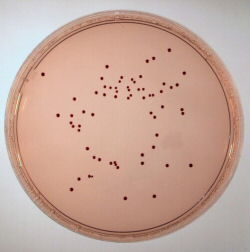

Maintaining a microbiologically safe water supply remains as important in high income countries as it is in the developing world.
Microbiology specialist Lab M offers a comprehensive range of dehydrated culture media, including chromogenic agar and media supplements, specifically designed to aid water supply management. The range includes media for detecting coliforms including Escherichia coli, for isolation of enterococci, Legionella detection, and for performing total viable counts - a portfolio that helps ensure reliable results and compliance with evolving standards.
For coliforms and E. coli, Harlequin™ mLGA chromogenic medium and Tryptone Bile Agar provide highly sensitive detection of faecal contamination of water. Both are used in determining the effectiveness of water treatment and disinfection regimes, and for monitoring water quality in the supply network.
For detecting enterococci, Slanetz & Bartley medium may be used for presumptive enumeration from water samples using a membrane filtration technique as described in ISO 7899-2:2000. Enterococci are confirmed by demonstrating aesculin hydrolysis on Kanamycin Aesculin Azide Agar.
For the isolation of Legionella from clinical and environmental samples BCYE Legionella Medium is used and is detailed in internationally recognised methodology (ISO 11731:1998) for the isolation of Legionella spp. from water. Specimens or samples are often heavily contaminated with other bacteria and Lab M supplies the selective supplement GVPC to aid the specific isolation of Legionella pneumophila.
For total viable counts Water Plate Count Agar (ISO) and R2A Medium are useful in assessing ground water integrity and the efficiency of water treatment processes, and when determining the suitability of a water supply for food and beverage preparation. R2A medium is recommended by the UK Environment Agency in Methods for the Examination of Waters and Associated Materials, and Standard Methods for the Enumeration of Water and Wastewater. Further information on Lab M's complete range of products for water testing can be found at www.labm.com